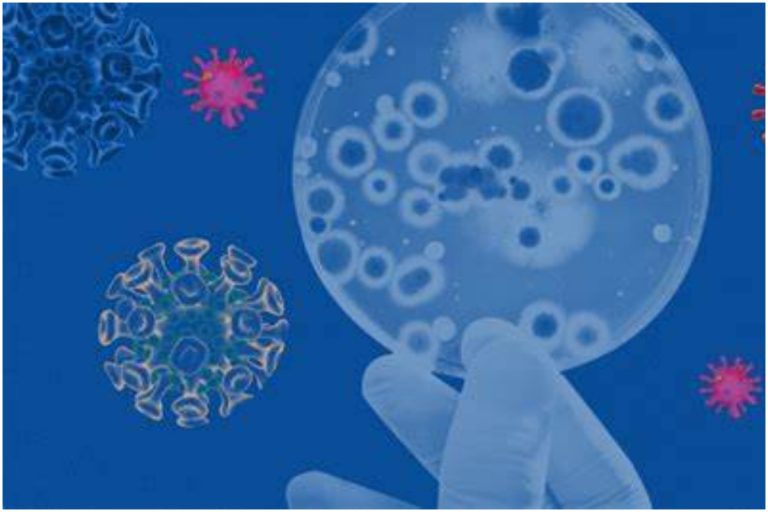
భారత్‌లో పెరుగుతున్న కోవిడ్, ఒమిక్రాన్ కేసులు

Home
Active Cases
Active Cases News
-
Covid-19: దేశంలో కోవిడ్ టెర్రర్.. 8 వేల చేరువలో కరోనా కేసులు
దేశంలో కరోనా విజృంభణ కొనసాగుతోంది. నిన్నటి వరకు ఆరు వేలలోపు నమోదు అయిన కేసులు తాజాగా 8 వేల చేరువ అయ్యాయి. భారత్లో గత 24 గంటల్లో 7,830 కొత్త కోవిడ్-19 కేసులు నమోదయ్యాయని కేంద్ర ఆరోగ్య మంత్రిత్వ శాఖ బుధవారం వెల్లడించింది. -
Covid Cases: దేశంలో తగ్గుముఖం పట్టిన కరోనా కేసులు
ఇండియాలో కరోనా కేసులు తగ్గుముఖం పట్టాయి. తాజాగా 24 గంటల్లో ఇండియాలో కొత్తగా 4,129 కరోనా కేసులు నమోదు అయ్యాయి. -
COVID19: ముంచుకొస్తున్న ఫోర్త్ వేవ్.. కొత్తగా 17,073 కరోనా కేసులు
దేశంలో కరోనా కేసుల సంఖ్య పెరుగుతోంది. ఫిబ్రవరి నుంచి మే వరకు రోజూవారీ కేసుల సంఖ్య కేవలం 5 వేలకు మాత్రమే పరిమితం అయ్యేది. కానీ ఇప్పుడు మాత్రం కేసుల సంఖ్య గణనీయంగా పెరిగింది. గత కొన్ని రోజుల నుంచి కేేసుల సంఖ్య పదివేలకు మించి నమోదు అవుతున్నాయి. తాజాగా సోమవారం కేంద్ర ఆరోగ్య శాఖ ప్రకటించిన గణాంకాల ప్రకారం గడిచిన 24 గంటల్లో ఇండియాలో 17,073 కొత్త కరోనా కేసులు నమోదు అయ్యాయి. ఇది ఆదివారంతో… -
Telangana: కరోనా కలకలం.. 2 వేలకుపైగా యాక్టివ్ కేసులు
దేశవ్యాప్తంగా కాస్త తగ్గుముఖం పట్టినా.. తెలంగాణలో మాత్రం మహమ్మారి కల్లోలం రేపుతోంది. కొవిడ్ కొత్త కేసుల సంఖ్య వేగంగా పెరుగుతున్నాయి. రాష్ట్రంలో మరోసారి కరోనా కొత్త కేసుల సంఖ్య రెండు వందలు దాటింది. కొవిడ్ యాక్టివ్ కేసుల సంఖ్య 2 వేల మార్క్ దాటింది. ప్రస్తుతం రాష్ట్రంలో 2 వేల 26 మంది కరోనా బాధితులు చికిత్స పొందుతున్నారు. గత 24 గంటల్లో రాష్ట్రంలో 19వేల 715 శాంపిల్స్ పరీక్షించగా, 236 మందికి పాజిటివ్ వచ్చింది. ఆదివారం… -
భారత్లో పెరుగుతున్న కోవిడ్, ఒమిక్రాన్ కేసులు
దేశంలో కోవిడ్ ముప్పు తొలగడం లేదు. గత కొంతకాలంగా తక్కువగా నమోదవుతున్న కేసులు తిరిగి పెరగడం ప్రారంభించాయి. క్రమంగా పెరుగుతున్న కోవిడ్ కేసులు ఆందోళన పెంచుతున్నాయి. తాజాగా 9195 కరోనా కేసులు నమోదయ్యాయి. యాక్టివ్ కేసులు 77,002 వున్నాయి. మరోవైపు దేశంలో క్రమంగా పెరుగుతున్నాయి ఒమిక్రాన్ వేరియంట్ కేసులు. దేశంలో మొత్తం 781 ఒమిక్రాన్ కేసులు నమోదయ్యాయి. దేశ రాజధాని ఢిల్లీ లో అత్యధికంగా 238 కేసులు నమోదు కావడంతో ఆందోళన కలుగుతోంది. నిన్నటి “కోవిడ్” కేసులు… -
తెలంగాణలో కొత్తగా 171 కరోనా కేసులు
రాష్ట్రంలో కొత్తగా 24 గంటల్లో 38,373 నిర్థారణ పరీక్షలు నిర్వహించగా కొత్తగా మరో 171 కేసులు నమోదయినట్టు వైద్యారోగ్య శాఖ ప్రకటించింది. దీంతో మొత్తం కేసుల సంఖ్య 6,71,000లకు చేరుకుంది. నిన్న కరోనాతో ఒకరు మృతి చెందారు. దీంతో మృతుల సంఖ్య 3,952కు చేరింది. మహామ్మారి నుంచి నిన్న 208 మంది కోలుకున్నారు. తెలంగాణలో ప్రస్తుతం 4,126 యాక్టివ్ కేసులు ఉన్నాయని వైద్యారోగ్య శాఖ తెలిపింది. ప్రజలు నిర్లక్ష్యంగా వ్యవహరించకుండా కరోనా జాగ్రత్తలు పాటించాలని కోరింది. వచ్చే…
తాజావార్తలు
-
Shreyas Iyer: ఓటమికి కారణాలు ఇవే.. తప్పులను నిజాయితీగా ఒప్పుకున్న శ్రేయస్ అయ్యర్..
-
Harmanpreet Kaur: ఆ తప్పే మా కొంపముంచింది.. ప్రతీ సారి ఇలానే జరుగుతోంది.. భావోద్వేగానికి లోనైన కెప్టెన్..
-
CM Chandrababu : ఐదు రోజుల సీఎం టూర్.. వరుసగా భారీ కార్యక్రమాలు
-
IND Vs IRE: ప్రపంచ ఛాంపియన్ను మట్టికరిపించిన ఐర్లాండ్.. సిరీస్ కైవసం..
-
Nimmala Ramanaidu : జగన్వి అన్నీ క్రెడిట్ చోరీ ముచ్చట్లే.. వెలిగొండను పూర్తి చేసేది చంద్రబాబే
ట్రెండింగ్
-
Smriti Mandhana: నీయవ్వ తగ్గేదేలే.. ఆస్ట్రేలియా అంటే బయపడుతామా?.. మా సత్తా ఏంటో చూపిస్తాం!
-
Kitchen Tips : ప్రెషర్ కుక్కర్ రబ్బర్ వదులై గ్యాస్ లీక్ అవుతుందా? ఈ సింపుల్ చిట్కాలు ట్రై చేయండి.!
-
Lunch Box Cleaning : లంచ్ బాక్స్ రబ్బరు మురికితో నల్లబడిందా..? ఇలా సింపుల్గా మెరిపించండి.!
-
Positive Energy at Home: ఇంట్లో నెగెటివ్ ఎనర్జీకి చెక్.. ఈ చిట్కాలతో పాజిటివ్ ఎనర్జీ మీ సొంతం.!
-
Mohanlal: ‘ఏజ్ ఈజ్ జస్ట్ నంబర్’.. ఇద్దరు హీరోయిన్లతో డాన్స్ అదరగొట్టిన మలయాళి మెగాస్టార్.!